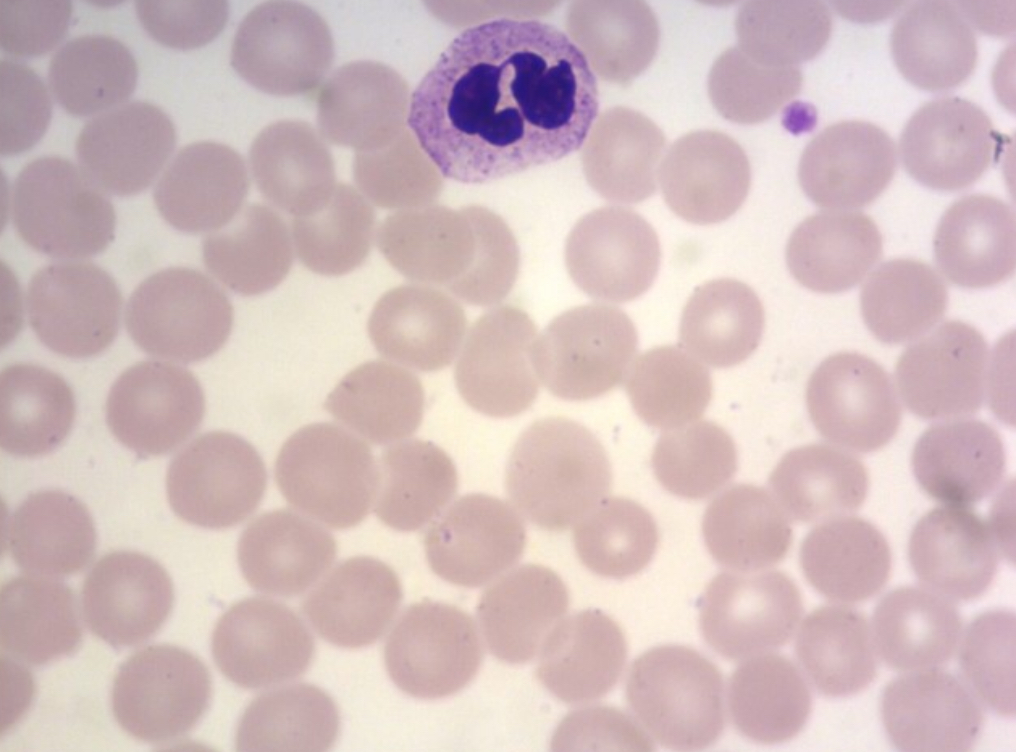

Which of the following is NOT a characteristic of fibrocartilage?
A. Type II collagen
B. Not surrounded by a perichondrium
C. Found in intervertebral discs
D. Increased collagen in the matrix
E. Neither A nor B are characteristic of fibrocartilage
A. Type II collagen
Fibrocartilage contains type I collagen B and E are incorrect because not being surrounded by a perichondrium is a characteristic of fibrocartilage.
Which of the following is not part of a Haversian system?
A. Lamellae
B. Volkmann canals
C. Periosteum
D. Canaliculi
E. Lacunae
C. Periosteum
Parathyroid hormone stimulates osteoblasts to secrete/express which of the following?
A. Osteoprotegerin
B. M-CSF
C. RANKL
D. All of the above
E. Only B and C
E. Only B and C (M-CSF and RANKL)
A “slipped” or herniated disc results when pressure on the vertebral column causes a displacement of the nucleus pulposus in the center of the disc which leads to a bulge caused by this displaced pressure. The weakend part of the disc that bulges out is the annulus ring that surrounds the nucleus pulposus. Which of the following types of tissues makes up this annular ring?
A. Hyaline cartilage
B. Fibrocartilage
C. Elastic cartilage
D. Woven bone
B. Fibrocartilage
Identify the tissue type.
A. Fibrous cartilage
B. Elastic cartilage
C. Hyaline cartilage
D. Membranous bone

C. Hyaline cartilage
Which of the following terms does NOT refer to mature bone?
A. Lamellar
B. Spongy
C. Compact
D. Woven
E. Cancellous
D. Woven
Flow of nutrients and oxygen to osteocytes depends on a system of passageways within the bone matrix itself. Which of the following are responsible for conducting these nutrients directly to the osteocytes embedded within the bone?
A. Haversian canal
B. Volkmann canal
C. Canaliculi
D. Capillaries
C. Canaliculi
In the attached photomicrograph, identify specific types of cells indicated by arrow and the type of bone formation shown here.
A. Chondroblasts and endochondral bone growth
B. Osteoclasts and endochondral bone growth
C. Osteoclasts and intramembrane bone formation
D. Osteoblasts and intramembrane bone formation

D. Osteoblasts and intramembrane bone formation
Identify the fine lines indicated by he letter “A”
A. Bile canaliculi
B. Haversian canaliculi
C. Elastic fibers
D. Collagen fibers

B. Haversian canalicul
In endochondral bone formation, deposition of bone matrix occurs on which of the following substrates?
A. Fibrous connective tissue
B. Chondroitin sulfate in hyaline cartilage matrix
C. Calcified hyaline cartilage matrix
D. Woven bone
C. Calcified hyaline cartilage matrix
During the develpment and growth of long bones, hyaline cartilage is replaced by bone. Which of the following activities would be directly responsible for the increase in the length of the bone?
A. Destruction of chondrocytes by the invasion of the ossification front.
B. Enlargement of chondrocytes in the hypertrophic zone.
C. Proliferation of chondrocytes away from the ossification front.
D. Generation of osteoblasts in the invasion zone.
C. Proliferation of chondrocytes away from the ossification front.
Which of the following is normally secreted by osteoblasts and binds to RANKL to prevent maturation of osteoclasts?
A. Calcitonin
B. Osteoprotegrin
C. Denosumab
D. Aγβ3 integrin
B. Osteoprotegrin
Reabsorption of bone matrix by osteoclasts involves removal of both the organic and the inorganic component of the matrix. Which of the following is secreted by osteoclasts to degrade the organic matrix of the bone?
A. Hydrogen and chloride ions
B. Osteopontin
C. Cathespin K
D. Osteoprotegrin
C. Cathespin K
Which of the following characteristics best characterizes the synovial membrane lining of a typical synovial joint cavity?
A. This membrane is highly vascularized and poorly innervated.
B. This membrane is highly vascularized and richly innervated.
C. This membrane is poorly vascularized and richly innervated.
D. This membrane is poorly vascularized and poorly innervated.
A. This membrane is heighly vascularized and poorly innervated.
The following photomicrograph shows a portion of an epiphyseal plate. The specific region of the growth plate indicated by the letter “B” represents which of the following growth plate zones?
A. Calcification zone
B. Proliferative zone
C. Reserve zone
D. Hypertrophic zone

D. Hypertrophic zone
Which of the following cell types have a bilobed nucleus and specific granules containing major basic protein that disrupts parasite membranes?
A. Basophils
B. Eosinophils
C. Neutrophils
D. Monocytes
E. Lymphocytes
B. Eosinophils
Of the the circulating blood cell types, which of the following is an active ameoboid phagocyte, characterized by numerous small specific granules and larger, less numerous azurophilic granules?
A. Eosinophil
B. Neutrophil
C. Basophil
D. Monocyte
B. Neutrophil
Identify the type of cell shown in this slide.
A. Lymphocyte
B. Neutrophil
C. Monocyte
D. Basophil
E. Eosinophil
B. Neutrophil
The large reddish blood cell shown in this photomicrograph represents which of the following kinds of cells?
A. Neutrophil
B. Basophil
C. Eosinophil
D. Lymphocyte

C. Eosinophil
Prothrombin is the inactive form of thrombin. It is activated by which of the following factors when the factor comes into contact with collagen in the damaged vessel wall?
A. Factor V
B. Factor X
C. Factor XII
D. Factor XIII
C. Factor XII
The lamina cribosa is associated with which of he following layers of the eyeball?
A. Cornea
B. Sclera
C. Choroid
D. Inner tunic
B. Sclera
The non-photosensitive area of the retina lies anterior to which of the following landmarks?
A. Limbus
B. Ciliary body
C. Canal of Schlemm
D. Ora serrata
D. Ora serrata
Cell bodies of bipolar cells horizontal cells, amacrine cells, and Mueller cells form which of the following layers of the retina?
A. Outer nuclear layer
B. Outer plexiform layer
C. Inner nuclear layer
D. Inner plexiform layer
C. Inner nuclear layer
Which of the following types of cells serve as interneurons that interconnnect ganglion cells and bipolar cells?
A. Mueller cells
B. Amacrine cells
C. Brunner cells
D. Horizontal cells
B. Amacrine cells